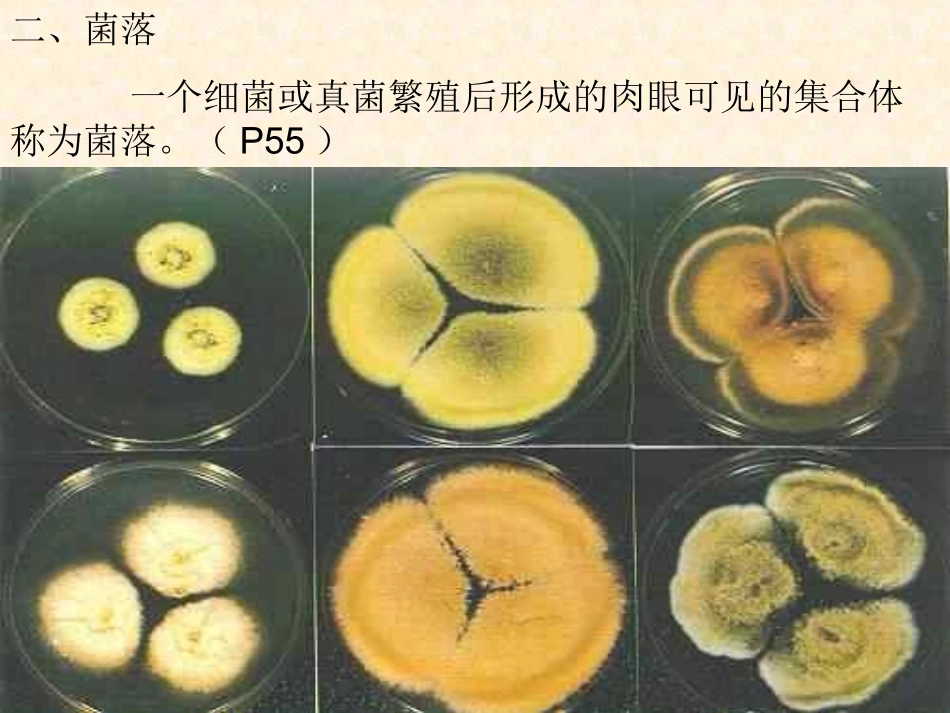
八年级生物人教版上册第5单元第4章 第一节 细菌和真菌的分布2_第3页

一、细菌和真菌在哪里
第一节细菌和真菌的分布鼻腔内的细菌口腔内的细菌大肠杆菌脚气真菌酵母菌乳酸杆菌二、菌落一个细菌或真菌繁殖后形成的肉眼可见的集合体称为菌落
(P55)三、观察菌落:1、细菌菌落:小,光滑粘稠/粗糙干燥;2、真菌菌落:大,绒毛状、絮状、蜘蛛网状,多种颜色
(P55)四、培养细菌或真菌的一般方法:1、什么叫培养基:根据细菌或真菌生长时所需要的营养成分而配制成的营养物质
2、一般方法:⑴配制含有营养物质的培养基,进行高温灭菌然后冷却;⑵将少量细菌或细菌放在培养基上的过程叫接种;⑶然后将培养皿放在温暖或恒温装置里进行培养
1、一个细菌或真菌繁殖的后代形成的肉眼可见的集合体被称为:()A、菌群B、菌斑C、菌落D、菌痕C2、用无菌棉棒擦取手心,在培养基上轻轻涂抹,这个过程是:()A、制作培养基B、高温灭菌C、接种D、培养C3、想知道硬币上有无细菌,比较可行的检查方法是:()A、肉眼看B、放大镜C、光学显微镜D、培养基培养D4、在培养基上看见的哪种菌落是细菌:()A、菌落小,表面光滑B、菌落大,呈绒毛状C、菌落大,呈蛛网状D、颜色呈褐色、红色A五、探究细菌和真菌的分布:1、提出问题2、探究思路3、材料用具牛肉膏蛋白胨培养基:牛肉膏:3g蛋白胨:10g琼脂:15g水:1000mlNaCL:5gPH:7
61kg/cm蒸汽压灭菌30分钟,用于培养细菌(或真菌)4、提示:(3)、目的是设置对照
一套不做处理,为对照组;一套做处理,为实验组
(5)、在恒温箱中或室内温暖的地方培养;要在同一环境下培养
讨论:1、高温处理后,可以将培养皿上、培养基内混有的细菌或真菌的孢子杀死,这样就排除了实验外其他环境的污染
无菌棉棒:目的是为了防止棉棒上的微生物污染培养基
2、接种3、无处不在,各种环境中分布的多少不同,如手、硬币上附着的较多
4、经过严格高温灭菌的环境中
有,对照组,因